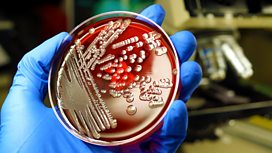

Main content
Drug Resistance
Why drug resistance is now regarded by the UK government as one of the most severe threats to public safety. Peter Marshall reports.
Producer: Lucy Proctor
Researcher: James Melley.
Last on
Thu 7 May 2015
20:00
麻豆社 Radio 4
![]()
Restarting the Antibiotic Pipeline
Roland Pease examines how an increasing number of antibiotics are failing.
![]()
The Truth About Statins
Tom Esslemont demystifies the debate surrounding the cholesterol-lowering drugs.
![]()
Superbugs
Can the NHS protect patients from new antibiotic-resistant superbugs?
Broadcast
- Thu 7 May 2015 20:00麻豆社 Radio 4
Download this programme
Subscribe to this programme or download individual episodes.
The Best of The Report
Listen again to the best investigations from The Report team